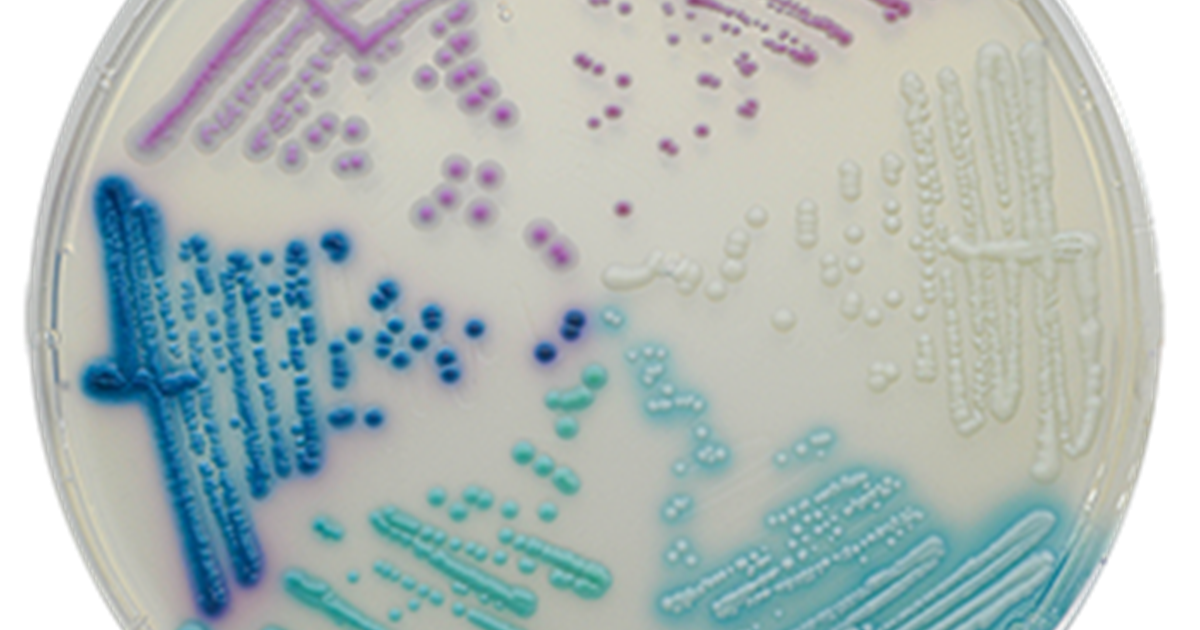
CHROMagar Candida Plus zum Nachweis von Candida auris

This Item Ships For Free!
Candida chromagar deals
Candida chromagar deals, Candida spp. on CHROMagar candida r microbiology deals
4.6
Candida chromagar deals
Best useBest Use Learn More
All AroundAll Around
Max CushionMax Cushion
SurfaceSurface Learn More
Roads & PavementRoads & Pavement
StabilityStability Learn More
Neutral
Stable
CushioningCushioning Learn More
Barefoot
Minimal
Low
Medium
High
Maximal
Product Details:
Diagnostics Free Full Text Usefulness of Chromogenic Media deals, CHROMagar Candida Plus zum Nachweis von Candida auris deals, Candida Albicans Grow On Chromagar Candida Stock Photo 1158135367 deals, Candida spp. on CHROMagar candida r microbiology deals, shows CHROM agar Candida with different isolation of Candida deals, CHROMagar Candida Chromagar deals, Candida auris the next public health emergency Chromagar deals, Microbe Notes I Candida albicans II Candida glabrata III deals, Media Mage Media Mage is the sole supplier of CHROMagar deals, CHROMagar ImTec Diagnostics NV deals, 25 Chromagar Candida Royalty Free Photos and Stock Images deals, Use of CHROMagar in the Differentiation of Common Species of deals, CHROMagar Candida Plus Chromagar deals, PDF Application of CHROMagar candida A New Differential deals, View of Speciation of Candida using CHROMagar isolated from deals, CHROMagar Candida Plus Chromagar deals, 25 Chromagar Candida Royalty Free Photos and Stock Images deals, Candida glabrata An Overview deals, CHROMagar Microbiology LinkedIn deals, Chromagar PDF Candida Fungus Staphylococcus Aureus deals, JCDR Antifungal susceptibility testing Candida CHROMagar deals, Colonies of different species of Candida after growing for 48 h at deals, Product CHROMagar Candida 5000 ml Copenhagen Biotech Supply deals, Candida spp. on CHROMAgar Candida Microbiology Candida albicans deals, The colors of Candida species in CHROMagar Candida chromogenic and deals, Diagnostics Free Full Text Usefulness of Chromogenic Media deals, CHROMagar Candida Chromagar deals, PDF USE OF CHROMOGENIC MEDIUM FOR SPECIATION OF CANDIDA ISOLATED deals, Chromagar Candida deals, CHROM agar showing different species of Candida a C.albicans b deals, Growth of different Candida species on Chromagar plate. Download deals, CHROMagar Candida Use composition preparation colony morphology deals, CHROMagar Candida Plus Chromagar deals, CHROMagar Candida Chromagar deals, CHROMagar Candida Chromagar deals, Product Info: Candida chromagar deals.
- Increased inherent stability
 - Smooth transitions
 - All day comfort
 
Model Number: SKU#7372201